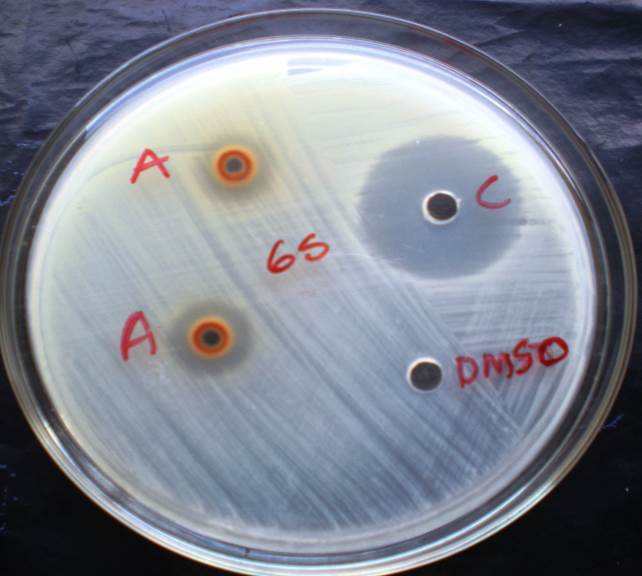
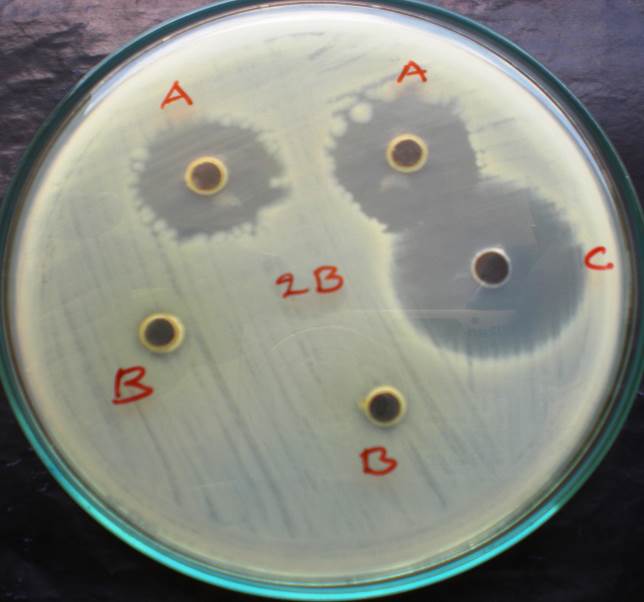
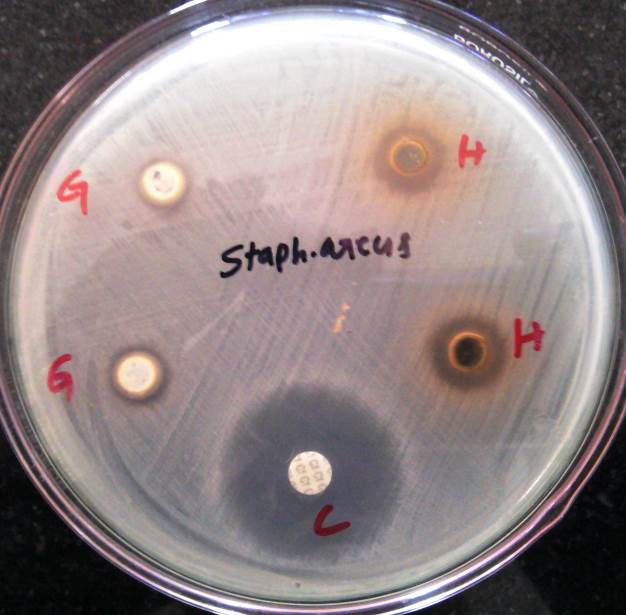
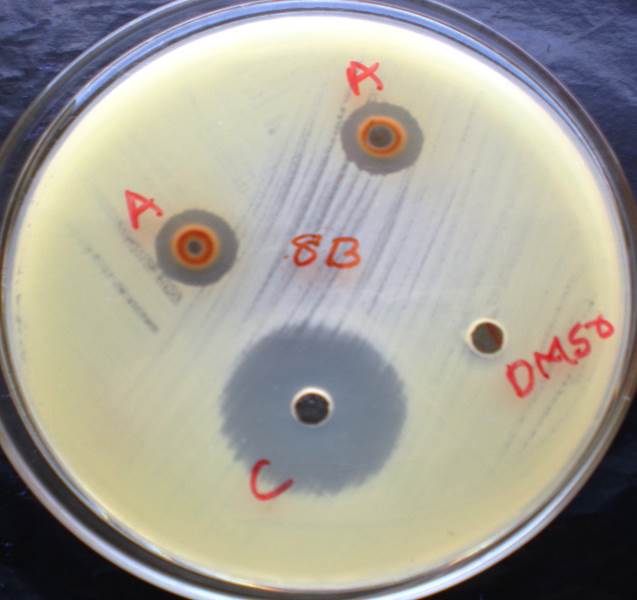

Department of PG and Research Biotechnology, J. J. College of Arts and Science, Pudukkottai, Tamil Nadu 622001
Email: laxman.mphil@gmail.com
Received: 28 Dec 2016, Revised and Accepted: 27 Mar 2017
ABSTRACT
Objective: In vitro investigated the potential of methanol extracts of micro-propagated C. orchiodes in the antimicrobial property against the three gram-negative bacteria, two gram-positive and one fungal filament.
Methods: The micro propagated callus methanol extract was examined against Escherichia coli, Proteus vulgaris, Salmonella typhimurium, Pseudomonas aeruginosa, Staphylococcus aureus, Bacillus cereus and Candida albicans. The zone of inhibitions are determined at 10 mg/ml concentration of methanol extracts of callus on agar well plate and MIC against tested microorganism.
Results: The highest antibacterial activity recorded in Staphylococcus aureus Bacillus cereus and followed by Candida albicans. Antibacterial activity of leaf extracts of A. reticulata was also significant against the tested microorganisms Escherichia coli, Salmonella typhi, Proteus vulgaris, Pseudomonas aeruginosa compared to ciprofloxacin.
Conclusion: Based on the above observations, these extracts were further evaluated for their effect on microorganisms causing infections like typhoid fever, urinary tract infections, septicemia, toxic shock syndrome, skin infection, nosocomial infection, arthritis and diarrhoea. The results also suggest that these plants serve a therapeutic purpose in the treatment bacterial infections.
Keywords: Antimicrobial activity, Curculigo orchioides, Micro propagted callus extract, Agar well diffusion method, Minimum inhibitory concentration (MIC).
© 2017The Authors. Published by Innovare Academic Sciences Pvt Ltd. This is an open access article under the CC BY license (http://creativecommons.org/licenses/by/4.0/)
DOI: http://dx.doi.org/10.22159/ijcpr.2017v9i3.19581
The world health organization reported approximately 80% of the world’s population still relies on traditional plant medicines for the treatment of some chronic diseases and common illness [1]. The bacterial strains developed its genetic ability to various pharmacological antibiotics. The synthesized drugs associated with adverse effects which lead to immunosuppression and allergic reactions. The formulation of appropriate and efficient antimicrobial drugs to the patient is the ultimate goal in this decade. Plants are traditionally used in the treatment of bacterial and fungal infections for its wide range of bioactive molecules. Phytochemicals are applied as natural anti-pathogenic which can be derived from leaves, stems, barks and flowers of plants. The traditional plant medicine is getting back with modern science all over the globe. The extracts from medicinal plants are used in the treatment of different diseases of humans, plants and animals [2].
Curculigo orchioides gaertn. of Amaryllidaceae is known as golden eye grass or Black Musale in English, Kalimusli in Hindi. Rootstock or rhizome, leaf, root or whole plant. C orchioidedes is known as musali or talamuli in Ayurveda and nilapani in Siddha system of medicine [1]. The genus C. orchioidedes consist of 10 species, out of which 3 species are found in India. C. orchioidedes is an acaulescent herb found in the sub-tropical Himalayas from kumaun eastwards to khasia hill, Manipur, bihar, chota Nagpur, west Bengal Tamilnadu and estern ghats, the root tuber is used in siddha system for the treatment of diseases like diabetes, leucoderma, pain, including cancer and as an aphrodisiac [2].
The root stock is mucilaginous, sweet, cooling, bitter, emollient, diuretic, aphrodisiac, depurative, alternative, appetiser, carminative, viriligenic, antipyretic and tonic. Bhavamisra described it as generally strength-giving and aphrodisiac. The plant extract of C. orchioides showed hypoglycemic, spasmolytic and anticancer properties. It is also useful in pruritus, skin diseases, asthma, bronchitis, jaundice, diarrhoea, cuts and wounds, colic, vomiting, erectile impotence, spermatorrhea, general weakness, burning, fatigue, piles and menorrhagia. The uterine stimulant activity of the flavone glycoside of C. orchioides has been studied. Phagocytic activity and immunoadjuvant activity of phenolic glycosides, curculigoside from the rhizome have been reported. The medicinal importance of C. orchioides in indigenous system of medicine as a tonic and also reported as an ayurvedic food supplement against dimethylbenzanthracene-induced mammary tumours in rats [3, 4]. The modulation of male infertility ayurvedic drug contained. C. orchioides. Immunostimulant activity of C. orchioides has been demonstrated 28, 29.
Chopra and Misra et al. reported that the extracted black musale has also been used as a tonic to overcome impotency. The active compounds that have been reported are flavones, glycosides, steroids, saponins, triterpenoids and other secondary metabolites [5, 6]. Therefore, the plants have long since been deemed a valuable source of natural products for maintaining human health.
Bolda reported that the plant tissue culture technology offers an effective method for enhancement of secondary metabolites by micropropagation of callus, which are in high demand for their therapeutic value. It has been reported that callus and regenerated plants have shown enhancement of secondary metabolites when compared to natural products [6].
In the present study, we investigated the potential of methanol extracts of micro-propagated C. orchiodes in the antimicrobial property against the three gram-negative bacteria, two gram-positive and one fungal filament.
Extraction procedure
Shade dried callus parts were reduced to fine powder and 10g of powder was taken into a 250 ml conical flask and 100 ml of methanol was added. After thorough mixing the flask was kept on a rotary shaker at 190–220 r/min for 48 h and it was filtered through Whatman filter paper No1. (WHATMAN Ltd., England). The filtrate was evaporated until dry in a water bath at 80 °C temperature. The crude extract was prepared by dissolving the known amount of the dry extract in dimethyl sulfoxide (DMSO; Merck Specialties Private Limited, Mumbai, India), to have a stock solution of 10 mg/ml concentration and stored at 4 °C.
Bacterial culture
A total five microorganisms were used to assess the antibacterial properties, it includes two gram–positive bacteria, four-gram negative bacterial and one fungal filament such as Escherichia coli, Salmonella typhi, proteus vulgaris, pseudomonas aeruginosa, Staphylococcus aureus Bacillus cereus and Cndida albicans. The microorganisms originally obtained from microbial collection centre, Institute of Microbial Technology, Chandigarh, India.
Methods
Agar well diffusion method
The agar well diffusion assay described by Perez et al. (1990) was adopted. Briefly, 0.1 ml of diluted inoculums (2 x 108 CFU/ml) of test organism was spread on Muller-Hinton agar plates. Wells of 6 mm diameter were punched into the agar and filled with 10 µl of plant extract of 10 mg/ml concentration and solvent blank (DMSO) separately. The plates were incubated at 37 °C, overnight. Ten µl of ciprofloxacin at 5 μg/ml concentration was used as positive control. Zone of inhibition of test organism growth around each well was measured in mm. Each test was carried out in triplicate.
Determination of minimum inhibitory concentration (MIC)
The MIC of the individual extract was determined using serial microplate dilution method of Eloff (1998) with few modifications. Acetone extracts of selected indigenous plants and spices were dissolved in DMSO to give a stock concentration of 10 mg/ml, while the antibiotic ciprofloxacin used as a positive control was dissolved in ultrapure water to give a stock concentration of 5 mg/ml.
Two-fold serial dilution of test extracts (100 μl) in sterile normal saline was prepared in 96-well microtitre plate and 50 µl overnight fresh bacterial culture suspensions were adjusted to 0.5 McFarland standard turbidity unit were added to each well (Bassole, et al., 2003). The plates were incubated overnight at 37 °C and bacterial growth was detected by adding 20 μl of p-iodonitrotetrazolium violet (INT) to each well. After incubation at 37 °C for 30 min, INT is reduced to a red formazan by biologically active organisms, in this case, the dividing bacteria. The concentration of extract was taken as the MIC when there is the absence of red colour in the well due to inhibition of bacterial growth. Solvent controls and standard antibiotic ciprofloxacin were included in each experiment that was done in triplicate.
In the present study, the antimicrobial activity of the methanol extract of Curculigo orchioides callus was examined, both qualitatively and quantitatively at 10 mg/ml (100µg) concentration by the presence or absence of microbial growth, zone inhibition on agar well test plate. Results obtained in the present study by both qualitative and quantitative experiments relieved that the tested methanol extract of Curculigo orchioides callus possesses potential antibacterial activity against Escherichia coli, Salmonella typhi, Proteus vulgaris, Pseudomonas aeruginosa, Staphylococcus aureus Bacillus cereus and Candida albicans.
When tested by the disc diffusion method and MIC, the methanol extracts of the callus curculigo orchioides showed significant activity against all the tested microorganisms when compared with standard antibiotic ciprofloxacin (table 1 and 2). The highest antibacterial activity recorded in Staphylococcus aureus Bacillus cereus and followed by Candida albicans. Antibacterial activity of leaf extracts of A. reticulate was also significant against the tested microorganisms Escherichia coli, Salmonella typhi, Proteus vulgaris, Pseudomonas aeruginosa compared to ciprofloxacin.
The antimicrobial activity of the methanol extract of Curculigo orchioides callus against four-gram negative, two-gram positives and one fungi. The result from the antimicrobial well diffusion method summarised in the above table. the callus extract of Curculigo orchioides showed good inhibitory activity against only gram positive organisms like Stphylococcus aureus (15.0±1.0) (fig. 2), Bacillus cereus (14.0±1.5) (fig. 4) and average antibacterial activity against gram-negative organisms like Escherichicoli (10.2±1.0) (fig. 1), Salmonell typhi murium (12.0±1.0) (fig. 3), Pseudomonas aeruginosa (8.5±1.5) and Proteusvulgaris (11.0±1.5), however the methanol extract of 15.0±1.5 showed good zone of inhibition towards fungi (Candida albicans) (13.2±0.5). In particularly Curculigo orchioides callus showed a good significant zone of inhibition against grama negative organisms like Salmonell typhi murium than Escherichia coli. The effectiveness of inhibitors can be sequenced as follows in descending order against gram positive and gram negative by agar well diffusion assay.
According to table, the minimum inhibitory concentration (MIC) revealed that the callus of Curculigo orchioides 10 mg/ml extract was shown average antimicrobial activity against gram negative and gram positive while antifungal activity against candida albicans. The MIC values of 2.5 mg/ml for Escherichia coli (fig. 5), 0.625 mg/ml, 0.625 mg/ml for Proteus vulgaris (fig. 3.43), 0.3125 mg/ml for Salmonella typhimurium(fig. 5),, 1.25 mg/ml for Pseudomonas aeruginosa, 1.25 mg/ml for Staphylococcus aureus (fig. 5),, 0.0781 mg/ml for Bacillus cereus (fig. 5) and 0.1562 mg/ml for Candida albicans. The effectiveness of MIC can be sequenced as follows in descending order against gram positive and gram negative.
Table 1: Antimicrobial activity of the methanol extract of Curculigo orchioides callus (10 mg/ml of DMSO crude extract of each part of callus and final concentration 100µg concentration in well) and antibiotic (10 µg/ml) against gram positive, gram negative and fungal microbial species tested by using agar well diffusion Diameter of Zone of inhibition (mm)
| Microorganisms | Callus extract | Ciprofloxacin |
| Escherichia coli | 10.2±1.0 | 20.0±0.5 |
| Proteus vulgris | 11.2±1.0 | 20.0±0.5 |
| Salmonell typhu murium | 12.0±1.5 | 20.0±0.58 |
| Pseudomons aeruginosa | 8.5±1.0 | 18.0±0.55 |
| Staphylococcus aureus | 15.0±1.0 | 25.0±0.5 |
| Bacillus cereus | 14.0±1.5 | 23.0±0.5 |
| Cndida albicans | 13.2±1.5 | 25.0±1.52 |
Note: Values of the observed zone of inhibition (in mm diameter) including the diameter of well (6 mm) after 24 h incubation against different bacterial species when subjected to different extracts in agar well diffusion assay. The assay was performed in triplicate and results are the mean of three values±Standard Deviation. In each well, the sample size was 10 µl. Inhibition observed in extracts due to solvent were assessed through negative controls. “–“No Inhibition Zone was observed. “Cf.”-Ciprofloxacin (5 µg ml-1) was used as a standard antibiotic. Values are the average triplicate; includes the agar well diameter (6 mm).
Table 2: Minimum inhibitory concentration (MIC) of methanol extract of Curculigo orchioides callus (10 mg/ml of DMSO crude extract each part of plant, (1000 µg concentration) and ciprofloxacin antibiotic (10 µg/ml) against gram negative, gram positive and fungal microbial species tested by using ELISA microtiter plate
| Microorgnisms | Callus extract | Ciprofloxacin |
| Escherichia coli | 2.5 | 0.1562 |
| Proteus vulgris | 0.625 | 0.3125 |
| Salmonell typhu murium | 0.3125 | 0.0781 |
| Pseudomons aeruginosa | 1.25 | 0.0390 |
| Staphylococcus aureus | 1.25 | 0.1562 |
| Bacillus cereus | 0.0781 | 0.0781 |
| Cndida albicans | 0.1562 | 0.0195 |
Methanol extract of Curculigo orchioides callus
Fig. 1: Antibacterial activity of the methanol extracts callus of Curculigo orchioides and C. ciprofloxacin antibiotic against Escherichia coli
Fig. 2: Antibacterial activity of the methanol extracts callus of Curculigo orchioides and C. ciprofloxacin antibiotic against Staphylococcus aureus
Fig. 3: Antibacterial activity of the methanol extracts callus of Curculigo orchioides and C. ciprofloxacin antibiotic against Salmonell typhu murium
Fig. 4: Antibacterial activity of the methanol extracts callus of Curculigo orchioides and C. ciprofloxacin antibiotic against Bacillus cereus

Fig. 5: Minimum Inhibitory Concentration of the methanol extracts callus of Curculigo orchioides against A. Staphylococcus aureus, B. Escherichia coli, C. Pseudomonas aeruginosa, D. Bacillus cereus and E. Salmonell typhi murium
Rows A, B and C: methanol extracts callus of Curculigo orchioides (compound in serial dilution+broth culture (A. Staphylococcus aureus, B. Escherichia coli and C. Pseudomonas aeruginosa, D. Bacillus cereus and E. Salmonell typhi murium+saline+INT indicator)
Rows F: only saline
Row G: Normal saline+broth culture+Indicator Row
Row H: Ciprofloxacin in serial dilution+broth culture+saline+INT indicator)
In ancient times, herbal medicines are only sources for treating various ailments in India. Nowadays, in addition to other treatments available, plants are becoming principle form of medicine in developing countries. Several antibiotics used in the treatment of various infections have limited antimicrobial spectrum, developed drug resistance in pathogens and lead to serious ill effects. Efforts were directed to identify plant products, which have broad species of therapeutically important higher plants, which were listed and described in the ancient Indian treatise have the antimicrobial activity. The urge and need to find out a broad-based inexpensive and alternate health care system have kindled interest and promoted studies on traditionally claimed medicinal plants [7].
The present study is an attempt to evaluate the antimicrobial activities of the methanol extracts of in vitro propagated callus of Curculigo orchioides. The method used for the evolution of antimicrobial activity was agar well diffusion method (qualitative) Minimum Inhibitory Concentration (Quantitative). The concentration of the each plant extracts 10 mg/ml DMSO for the antimicrobial activity. Xu et al. reported the antimicrobial activity of the rhizome may be due to the presence of phenolic active compounds in C. orchioides [8]. Vinoth et al. (2012) reported predominant antibacterial activity in the organic solvent as compared to water, which indicates that the active compounds responsible for the bactericidal activity are more soluble in the organic solvents.
According to Bai, (1990), the effectiveness of the plants was not due to one constituent, but to the combined action of other chemical compounds involved in it. Bioactive compounds like alkaloids, flavonoids as antimicrobial compounds [9]. Based on the results in this study by qualitative and quantitative methods, among all the test organisms of gram-positive organisms (table 1 and 2) like Staphylococcus aureus and Bacillus cereus and candida albicans were broad sensitive to the methanol extracts of in-vitro propagated callus of Curculigo orchioides than the gram-negative organisms (table 1 and 2) like Escherichia coli, Proteus vulgaris, Salmonella typhi murium and Pseudomonas aeruginosa. methanol extracts of in-vitro propagated callus of Curculigo orchioides was also showed significant antimicrobial activity against gram-positive organisms like Staphylococcus aureus Bacillus cereus and Candida albicans while same callus extract was showed moderate antifungal activity except methanol extracts of in-vitro propagated callus of Curculigo orchioides at 10 mg/ml concentration, because gram-negative organisms have phospholipid membrane in addition to the inner peptidoglycan layer, which makes the cell more impermeable for exogenous molecules in gram-negative organisms [10]. In this investigation, the important methanol extracts of in-vitro propagated callus of Curculigo orchioides showed strong antimicrobial activity against both gram positive and gram negative organisms by both qualitative and quantitative methods.
The antimicrobial activity of the callus of Curculigo orchioides may be due to the presence of phenolic active compounds in Curculigo orchioides [11]. Was more effective against Gram-positive and Gram-negative strains than other fractions. The reason may be that different solvents have varying degrees of solubility for different phytoconstituents [12]. Nevertheless, the present study suggests that the methanol extracts of in vitro propagated callus of Curculigo orchioides possesses significant antibacterial activity at very low concentrations against the pathogenic Gram-positive S. aureus bacteria. The results obtained might be considered for further studies aimed at isolating and identifying single active compounds within this phenols. The demonstration of antimicrobial activity against both Gram-negative and Gram-positive bacteria is an indication that the plant is a potential source for production of drugs with a broad spectrum of activity. The results of the study also support the traditional application of the plant and suggest the plant extracts possess compounds with antibacterial properties that can be used as antimicrobial agents. Further pharmacological evaluations, The results indicate that the methanol extract of in vitro propagated callus of Curculigo orchioides possesses potential antibacterial and antifungal compounds. High significance of the activity was exhibited against both gram positive and gram negative organisms by the qualitative and quantitative. Based on the above observations, these extracts were further evaluated for their effect on microorganisms causing infections like typhoid fever, urinary tract infections, septicemia, toxic shock syndrome, skin infection, nosocomial infection, arthritis and diarrhoea. The results also suggest that these plants serve a therapeutic purpose in the treatment bacterial infections.
It is concluded that this study would lead to the establishment of some valuable compound that has to be used to formulate new, different and more potent antimicrobial drugs of natural origin and by micropropagation of plant tissue culture technology. Further studies are needed to identify the biologically active compounds and to evaluate the efficiency of the compound against pathogenic microorganisms associated with various human diseases.
Declare none
How to cite this article